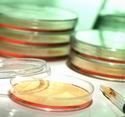
Portrét

Lapacho
Botanický popis :
Lapacho je označení pro odvar či čaj, který se získává převážně z lýkové a korové části rostliny jejíž botanický název je : Tabebuia impetiginosa (obr. 1), ale také z dalších druhů jako například Tabebuia ipe, T.avellanedea, T. nicaraguensis, T. schunkeuigoi, T. serratifolia, T. altissima, T. palmeri, Gelseminum avellanedea, Handroanthus avellanedea, H. impetiginosus, Tecoma adenophylla, Tecoma avellanedae, Tecoma eximia, Tecoma impetiginosa, Tecoma ipe. Tyto rostliny jsou botaniky řazeny do čeledi Bignoniaceae. Tabebuia impetiginosa je obrovský baldachýnový strom, který může dosahovat vzrůstu až 30ti metrů a průměru kmene při zemi až 3 metry. Jeho původní domovinou jsou deštné pralesy oblastí Amazonie a Latinské Ameriky, zejména Brazílie, Argentiny a Paraguaje. Kvete purpurově zbarvenými květy a má vícečetné kopinaté listy. V oblastech své domoviny je po staletí hojně využíván pro své léčebné účinky, jako okrasná dřevina, pro své purpurově zbarvené květy, a v dřevařském průmyslu pro značnou tvrdost a odolnost svého dřeva. Může dosahovat věku i přes 700 let. Rod Tabebuia čítá okolo 100 zástupců, kdy většina z nich se v léčitelství a farmacii může zaměňovat pro velmi podobný „fytochemický make up“, tedy přítomnost stejných obsahových látek.
Historie:
Možnost farmakologického, nebo dříve spíše léčitelského využití těchto stromů, ve své domovině tradičně nazývaných Pau D‘arco, byla experimentálně objevena již před obdobím vlády Inků, kteří ovšem využívání těchto stromů značně rozšířili, a podle nichž je odvar stromu tradičně nazýván čajem Inků, dále se mu také říká lapacho, taheebo, ipe roxo, mato grosso či trumpet tee... Některé paraguayské kmeny indiánů dodnes nazývají stromy rodu Tabebuia jako „tajy“, což znamená „mít sílu a ráznost“. Tradičně je v lidovém léčitelství užívání lapacha spojováno s jeho: protizánětlivým, antibakteriálním, antimykotickým, laxativním, antiulcerozním účinkem, ale i při léčení syfilisu, infekcí močových cest, svrabu, gastrointestinálních problémů, kandidózy, rakoviny, cukrovky, zánětů předstojné žlázy, alergií, a mnoha dalších chorob, takže je tento čaj pokládán téměř za všelék, což také demonstruje tabulka 1, která uvádí indikace a účinky, při a pro něž se lapacho v některých zemích využívá.
Obsahové látky a historie jejich výzkumu:
Seriozními výzkumy a chemickou analýzou byly jako hlavní obsahové látky nalezeny: Lapachol, a od něj odvozený b-lapachon, což je druhá z nejvýznamnějších a pro tuto drogu
Tradiční využívání Lapacha:
| Amazonie | Nachlazení, kašel, horečka, chřipka, leishmaniasis, bolesti, infekce močových cest |
| Argentina | Průjem, dýchací infekce, infekce močových cest |
| Bahamy | Bolesti v kříži, dysurie, anuréza, kapavka, bolesti zubů |
| Brazílie | Alergie, analgetikum, činidlo zabraňující srážení krve, proti houbám, bakteriostatikum, antimutagen, artritida, astma, svíravý prostředek, noční pomočování, burzitidu, rakovinu, kvasinkové infekce, látku podporující hojení jizev, nachlazení, kolitida, zácpa, zánět močového měchýře, cukrovky, močopudná látka, dyzentérie, ekzém, horečka, chřipka, zánět žaludku, gingividita, hernie, hemoroidy, krvácení, herpesy, Hodgkinova choroba, lišej, svědivost, leishmaniasis, leukémii, malárie, zánět předstojné žlázy, dýchací obtíže, revmatismus, plísně, svrab, uštknutí, bolení v krku, stomatitida, příjice, vředy, infekce močových cest, dělohy, pochva, křečové žíly, bradavice, zranění |
| Kostarika | Rakovina, nachlazení, horečka, bolest hlavy, uštknutí |
| Mexiko | Chudokrevnost, horečka |
| Jižní Amerika | Alergie, chudokrevnost, antibakteriální, antimykotický, protizánětlivý prostředek, artritida, svíravý prostředek, rakovina, kolitida, nachlazení, zácpa, kašel, zánět močového měchýře, cukrovka, průjem, dyzentérie, anuréza, horečka, chřipka, zánět žaludku, gastrointestinalní infekce, projímadlo, malárie, zánět hltanu, zánět předstojné žlázy, dýchací choroby, uštknutí, příjice, vředy, zranění |
| Spojené státy | Alergie, analgetický, antibakteriální, antimykotický, protizánětlivý prostředek, antimutagen, antioxidant, anti-parazitní, protivirový prostředek, artritida, rakovina, kvasinky, cirkulační poruchy, cukrovka, dyzentérii, horečka, chřipka, plísňové infekce, gastrointestinální infekce, Hodgkinova nemoc, infekce, projímadlo, leukémie, sžíravé vředy, zánět kosti a kostní dřeně, Parkinsonova choroba, zánět předstojné žlázy, svrab, dýchací problémy, pleťová hnisání, příjice, vředy, infekce močových cest, bradavice |
Mechanismus účinků:
Obě tyto látky lze po chemické stránce zařadit do skupiny naftochinonů. Vykazují především inhibiční účinky na enzym DNA – topoizomerázu 1, čímž se tyto látka řadí mezi slibná antivirotika a protirakovinná léčiva. Topoizomerázové inhibitory, včetně b-lapachonu a lapacholu, se zdají být účinné především proti několika typům rakoviny, včetně rakoviny plic, hrudníku obecně, prostaty a rovněž velmi nebezpečných melanomů. Použití b-lapachonu, jež je dnes pokládán, za významnější léčivé agens než lapachol, u lidí je ovšem velmi omezené z důvodu jeho značné toxicity. Dnes se testuje i 3-allyl-b-lapachone (blízký chemický příbuzný), který má obdobné účinky, ale vykazuje podstatně menší cytotoxicitu. Mechanismus účinku b-lapachonu spočívá v přerušení replikace DNA. Topoizomeráza je enzym, který odvíjí DNA z rigidní struktury chromozomu, protože pouze „uvolněnou“ DNA, je buňka schopná využít jako genetickou informaci pro syntézu proteinů. Inhibicí topoizomerázy 1 drží b-lapachon DNA těsně u sebe a nedochází tedy k syntéze bílkovinných molekul. Následkem toho buňka zastavuje dělení a růst. Vzhledem k tomu, že rakovinné buňky rostou a reprodukují se mnohem rychleji, než běžné somatické buňky jsou mnohem vnímavější k inhibičnímu účinku b-lapachonu na topoizomerázu 1. b-lapachon také zasahuje do replikace HIV 1 viru, který způsobuje AIDS, a tím zpomaluje vzestup choroby.
Nežádoucí účinky:
Problémem této velmi zajímavé aktivity je to, že stále nebyla u lidí dostatečně ověřena a proto velká řada autorů pokládá lapacho stále za placeno bez léčivých účinků a navíc byly při vyšších dávkách zaznamenány mnohé nežádoucí účinky, kde k nejvýznamnějším patří chudokrevnost a poruchy krevní srážlivosti (způsobené zvýšeným odbouráváním vitamínu K), velmi silné žaludeční potíže a v těhotenství až možnost vyvolání potratu. Příprava čaje: Pro přípravu čaje z lapacha nikdy nepoužíváme nádobu z hliníku, zinku apod. – vhodnějšími materiály jsou např. sklo, litina, varná keramika, porcelán nebo nerezové nádoby. Při vaření není vhodné používat k míchání plastové příbory a nedoporučuje se dokonce ani jeho skladování v plastikových nádobách. Mohlo by dojít k zeslabení požadovaných účinků. Základní recept ( pro cca 6 šálků ): nejdříve uvedeme do varu
Komentáře
Přehled komentářů
Je to skvělé, jen více takových článků.Určitě se budu na tuto stránku vracet.
Podpora této stránky
(Daniela Řeh., 9. 10. 2007 19:43)